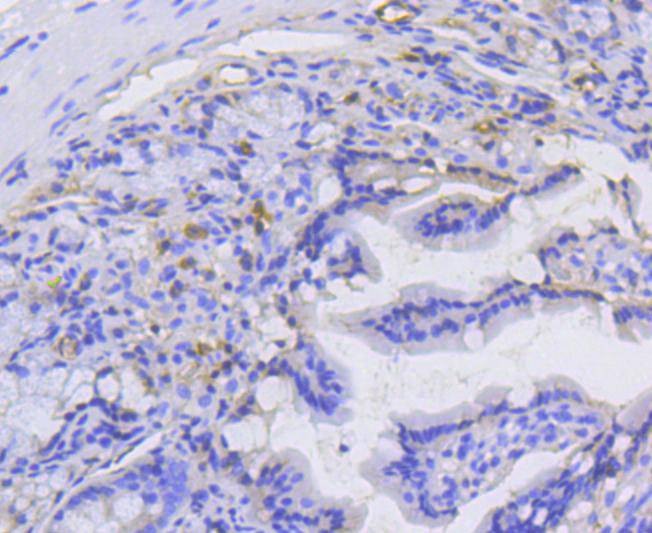

您的购物车当前为空
您的购物车当前为空
Anti-alpha 1 Catenin Antibody (9R277)
Synonyms: α1Catenin, α 1 Catenin, Renal carcinoma antigen NY-REN-13, Renal carcinoma antigen NY REN 13, OTTHUMP00000224147, OTTHUMP00000224141, NY REN 13 antigen, FLJ52416, FLJ36832, Ctnna1, CTNNA 1, CTNA1_HUMAN, Catenin alpha-1, Catenin alpha 1, Catenin (cadherin associated protein), alpha 1, 102kDa, Catenin (cadherin associated protein) alpha 1 102kDa, CAP102, CAP 102, Cadherin-associated protein, Cadherin associated protein 102kDa, Cadherin associated protein, alpha1Catenin, Alpha E-catenin, a1Catenin, a 1 CateninAnti-alpha 1 Catenin Antibody (9R277) 是一种 Rabbit 抗体,靶向 alpha 1 Catenin。Anti-alpha 1 Catenin Antibody (9R277) 可用于 FCM,ICC/IF,IHC,IP,WB。
Anti-alpha 1 Catenin Antibody (9R277)
一键复制产品信息别名 α1Catenin, α 1 Catenin, Renal carcinoma antigen NY-REN-13, Renal carcinoma antigen NY REN 13, OTTHUMP00000224147, OTTHUMP00000224141, NY REN 13 antigen, FLJ52416, FLJ36832, Ctnna1, CTNNA 1, CTNA1_HUMAN, Catenin alpha-1, Catenin alpha 1, Catenin (cadherin associated protein), alpha 1, 102kDa, Catenin (cadherin associated protein) alpha 1 102kDa, CAP102, CAP 102, Cadherin-associated protein, Cadherin associated protein 102kDa, Cadherin associated protein, alpha1Catenin, Alpha E-catenin, a1Catenin, a 1 Catenin
Anti-alpha 1 Catenin Antibody (9R277) 是一种 Rabbit 抗体,靶向 alpha 1 Catenin。Anti-alpha 1 Catenin Antibody (9R277) 可用于 FCM,ICC/IF,IHC,IP,WB。
| 规格 | 价格 | 库存 | 数量 |
|---|---|---|---|
| 50 μL | ¥ 1,480 | 5日内发货 | |
| 100 μL | ¥ 2,490 | 5日内发货 |
TargetMol的所有产品仅用作科学研究或药证申报,不能被用于人体,我们不向个人提供产品和服务。请您遵守承诺用途,不得违反法律法规规定用于任何其他用途。
产品介绍
| 产品描述 | Anti-alpha 1 Catenin Antibody (9R277) is a Rabbit antibody targeting alpha 1 Catenin. Anti-alpha 1 Catenin Antibody (9R277) can be used in FCM,ICC/IF,IHC,IP,WB. |
| 别名 | α1Catenin, α 1 Catenin, Renal carcinoma antigen NY-REN-13, Renal carcinoma antigen NY REN 13, OTTHUMP00000224147, OTTHUMP00000224141, NY REN 13 antigen, FLJ52416, FLJ36832, Ctnna1, CTNNA 1, CTNA1_HUMAN, Catenin alpha-1, Catenin alpha 1, Catenin (cadherin associated protein), alpha 1, 102kDa, Catenin (cadherin associated protein) alpha 1 102kDa, CAP102, CAP 102, Cadherin-associated protein, Cadherin associated protein 102kDa, Cadherin associated protein, alpha1Catenin, Alpha E-catenin, a1Catenin, a 1 Catenin |
| Ig Type | IgG |
| 克隆号 | 9R277 |
| 反应种属 | Human,Mouse,Rat |
| 验证活性 | 1. Western blot analysis of alpha 1 Catenin on different lysates using anti-alpha 1 Catenin antibody at 1/1,000 dilution. Positive control: Lane 1: Hela, Lane 2: HepG2, Lane 3: A431. 2. Immunohistochemical analysis of paraffin-embedded mouse colon tissue using anti-alpha 1 Catenin antibody. Counter stained with hematoxylin. 3. Immunohistochemical analysis of paraffin-embedded mouse prostate tissue using anti-alpha 1 Catenin antibody. Counter stained with hematoxylin. 4. Immunohistochemical analysis of paraffin-embedded mouse uterus tissue using anti-alpha 1 Catenin antibody. Counter stained with hematoxylin. 5. Flow cytometric analysis of Hela cells with alpha 1 Catenin antibody at 1/50 dilution (red) compared with an unlabelled control (cells without incubation with primary antibody; black). Alexa Fluor 488-conjugated goat anti rabbit IgG was used as the secondary antibody. |
| 应用 | FCMICC/IFIHCIPWB |
| 推荐剂量 | WB: 1:1000-2000; IHC: 1:50-200; ICC/IF: 1:50-200; FCM: 1:50-100 |
| 抗体种类 | Monoclonal |
| 宿主来源 | Rabbit |
| 构建方式 | Recombinant Antibody |
| 纯化方式 | ProA affinity purified |
| 性状 | Liquid |
| 缓冲液 | 1*TBS (pH7.4), 1%BSA, 40%Glycerol. Preservative: 0.05% Sodium Azide. |
| 研究背景 | α E-catenin (also designated α-catenin; cadherin-associated protein, α1, 102 kDa; and CAP102) plays a role in E-cadherin mediated cell-cell adhesion by linking E-cadherin to the cytoskeleton via β- or γ-catenin and Actin. α E-catenin connects cell-density-dependent adherens junctions with the developmental hedgehog pathway and may provide a negative feedback loop controlling the size of developing cerebral cortex. It is abundant in neuroepithelial precursor cells in the developing cortical ventricular zone of the brain, with reduced expression in the cortical plate. α E-catenin-vinculin interactions play a role in the assembly of the apical junction complex in epithelia. Catenins generally are thought to work as connectors that anchor E-cadherin to the cytoskeletal Actin bundle through the cadherin cytoplasmic domain. Dysfunction of this adhesion complex causes dissociation of cancer cells from primary tumor nodules, thus possibly contributing to cancer invasion and metastasis. |
| 偶联 | Unconjugated |
| 免疫原 | Recombinant Protein |
| Uniprot ID |
| 分子量 | Theoretical: 100 kDa. |
| 储存方式 | Store at -20°C or -80°C for 12 months. Avoid repeated freeze-thaw cycles. |
| 运输方式 | Shipping with blue ice. |





 还可以
还可以
 |
|